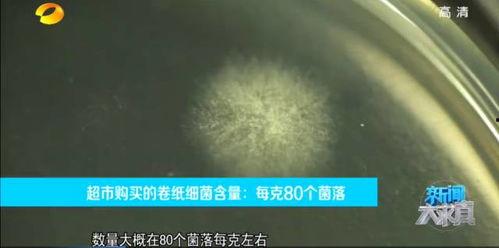

卫生纸新闻爆料,揭秘新闻爆料背后的真相
最近网上可是炸开了锅,关于卫生纸的新闻爆料,简直让人瞠目结舌!你有没有想过,我们每天离不开的卫生纸,竟然隐藏着这么多秘密?今天,就让我带你一探究竟,揭开卫生纸背后的那些事儿!
卫生纸的起源与发展
你知道吗?卫生纸的历史可追溯到古埃及时代。那时候,人们用纸莎草、麻布等天然材料来擦拭身体。而现代卫生纸的诞生,则要归功于19世纪末的美国发明家乔舒亚·惠特尼。他发明了一种机器,可以生产出柔软、吸水性能好的纸巾。从此,卫生纸走进了千家万户,成为了我们生活中不可或缺的用品。
卫生纸的种类与用途
卫生纸的种类繁多,有卷纸、抽纸、湿巾等。它们各自有不同的用途,比如:
1. 卷纸:这是我们最常见的卫生纸形式,主要用于如厕、擦拭等日常清洁。
2. 抽纸:小巧便携,适合外出携带,方便随时清洁。
3. 湿巾:含有清洁剂,可以用来擦拭手、脸等部位,尤其适合婴幼儿使用。
卫生纸的生产与环保
卫生纸的生产过程涉及到原材料的采集、加工、包装等多个环节。近年来,随着环保意识的提高,越来越多的卫生纸品牌开始关注环保问题。
1. 原材料:传统的卫生纸原材料是木材,而环保型卫生纸则采用竹浆、棉浆等可再生资源。
2. 加工工艺:环保型卫生纸在生产过程中,采用无污染、低能耗的工艺,减少对环境的影响。
3. 包装:部分卫生纸品牌采用可降解材料进行包装,减少塑料污染。
卫生纸的新闻爆料
最近,网上爆出一条关于卫生纸的新闻,让人瞠目结舌。原来,一些不良商家为了降低成本,竟然在卫生纸中添加了荧光剂、滑石粉等有害物质。这些物质对人体健康造成严重危害,长期使用可能导致皮肤过敏、呼吸道疾病等问题。
这条新闻一经曝光,立刻引起了广大消费者的关注。许多消费者纷纷表示,以后购买卫生纸时一定要仔细辨别,避免购买到有害产品。
如何辨别卫生纸的质量
为了避免购买到有害的卫生纸,以下是一些辨别卫生纸质量的方法:
1. 查看生产日期和保质期:确保卫生纸在保质期内。
2. 观察颜色:优质卫生纸颜色自然,无异味。
3. 手感:优质卫生纸手感柔软,吸水性能好。

4. 包装:正规品牌的卫生纸包装完整,标识清晰。

卫生纸作为我们日常生活中必不可少的用品,其质量直接关系到我们的健康。在购买卫生纸时,一定要选择正规品牌,关注环保问题,确保自己和家人的健康。同时,也希望相关部门能够加强对卫生纸市场的监管,让消费者用得放心。毕竟,健康才是最重要的!